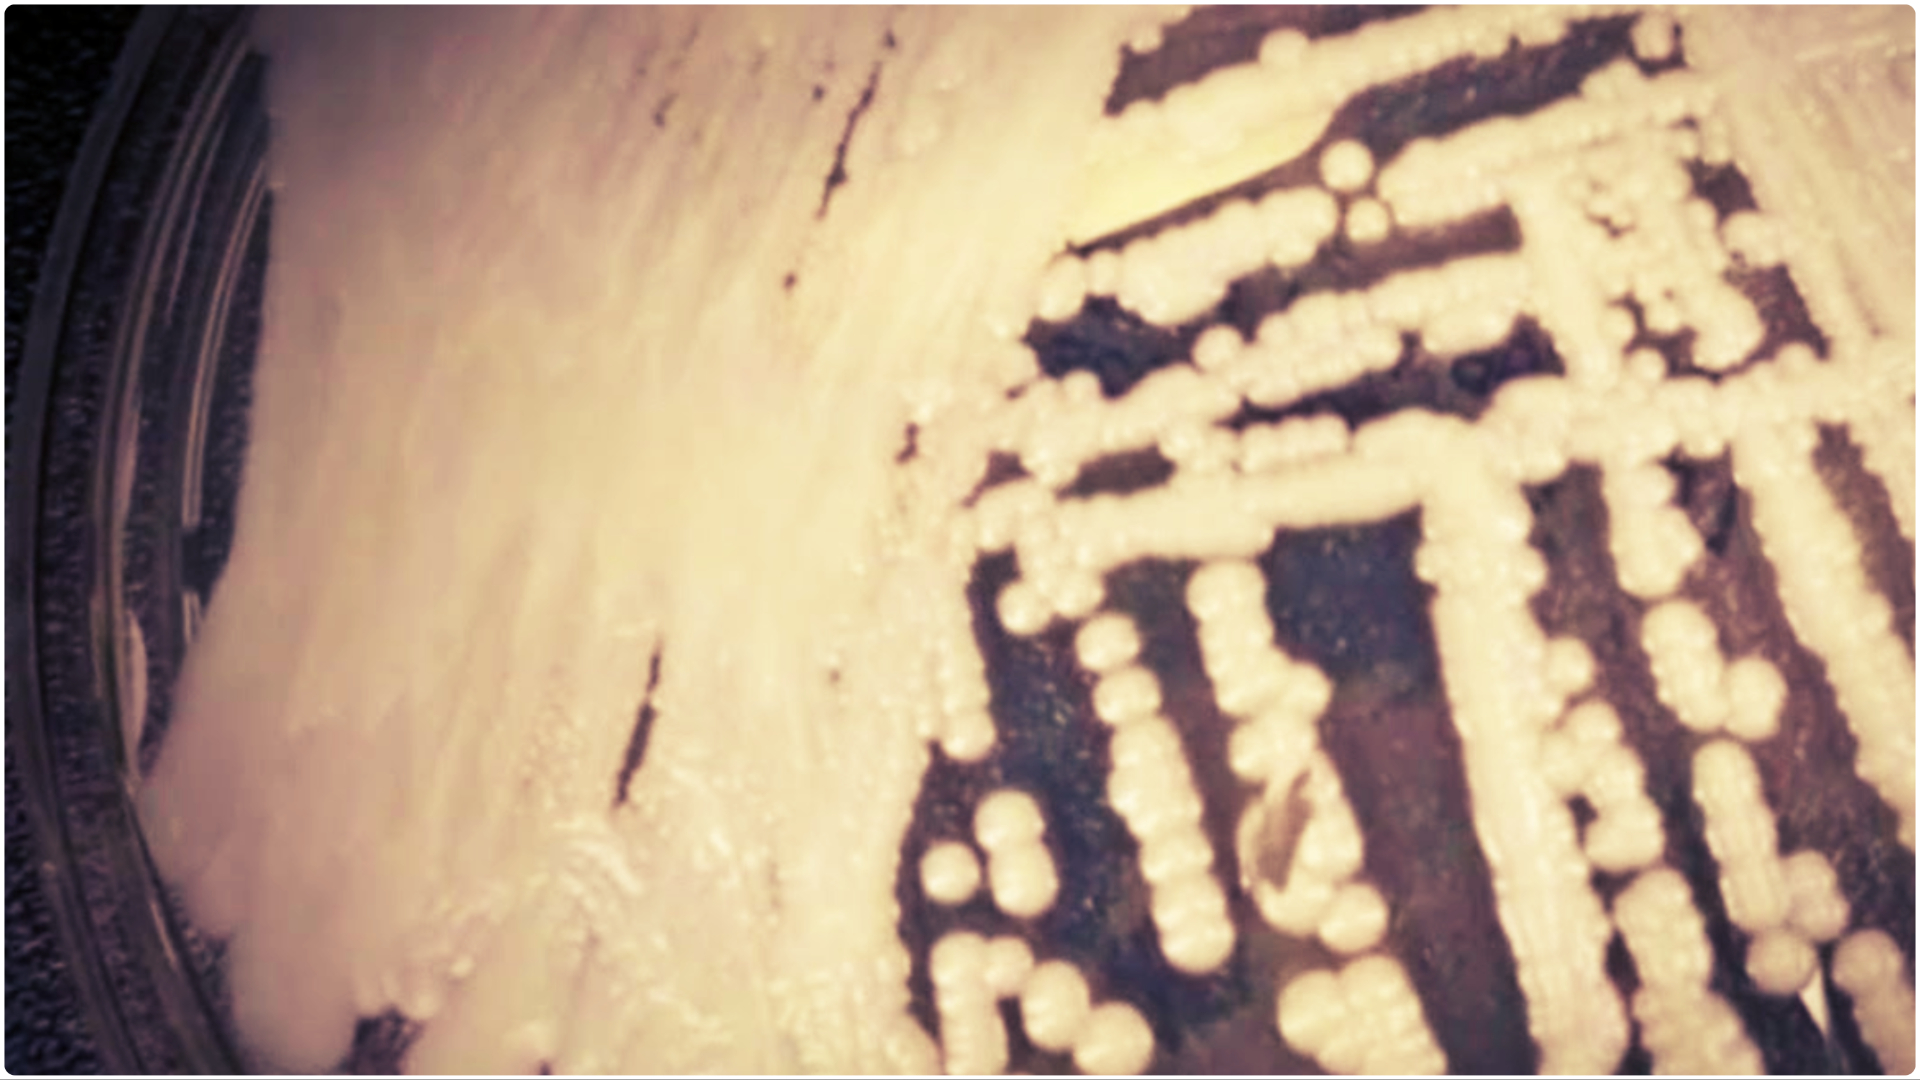

Drug-resistant Candida auris Fungus escapes containment, Invades Over Half of U.S. States
The Centers for Disease Control and Prevention (CDC) warns about the alarming spread of Candida auris, a drug-resistant fungus that poses a serious threat to public health. C. auris resists treatment by common antifungal medications, and more than half of the 50 states in the US have reported clinical cases of the fungus. The pandemic has worsened the spread of C. auris, with less attention given to screening and the reuse of personal protective gear.
In this article, we will provide information on C. auris, its spread during the pandemic, and what actions are being taken to contain it.
What is Candida auris?
- Candida auris is a type of fungus that can cause serious infections and is often resistant to antifungal medications. It was first reported in the US in 2016 and primarily preys on older people with weakened immune systems.
- C. auris can be found on the skin, clothing, and medical equipment and can be transmitted in healthcare facilities, making it difficult to control.
Spread of C. auris during the pandemic
- The CDC reports a dramatic increase in C. auris caseloads and transmission since the start of the pandemic. In 2021, state and local health departments reported 1,474 clinical cases, a 200% increase from the nearly 500 cases in 2019.
- The fungus is now in half the 50 states, with higher concentrations in California, Nevada, Texas, and Florida. The reuse of personal protective gear and less emphasis on screening during the pandemic worsened the spread of the fungus.
Why is C. auris a serious threat?
- Nearly half of patients who contract C. auris die within 90 days, according to the CDC. C. auris is not a particular threat to young and healthy people but can be transported on skin and clothing.
- The fungus commonly strikes older patients, particularly those who have many visits to health care facilities, where it can be hard to clean or eradicate. The challenge in treating C. auris stems from its resistance to antifungal medications, particularly echinocandins, which are frontline treatments.
- If resistance to echinocandins becomes more common, C. auris could become extremely difficult to treat, if not impossible.
Actions being taken to contain C. auris
- The CDC is taking steps to contain the spread of C. auris. Intensive efforts in New York and Illinois have been effective in containing the fungus within the healthcare systems in those states.
- The CDC recommends that healthcare providers screen patients for C. auris, particularly those who have stayed in hospitals abroad or for extended periods. Healthcare facilities should follow infection prevention and control practices to reduce the spread of the fungus.
The spread of Candida auris during the pandemic is alarming and poses a serious threat to public health. Healthcare facilities and the public should take necessary precautions to prevent the spread of the fungus. The CDC recommends increased screening, infection prevention, and control practices to contain the fungus.
If you have any questions regarding this article, feel free to ask in the comments below. For more content, stay with us, here at Spiel Times.
Make sure you subscribe to our push-notifications and never miss an update from the world of video games, cinema, and sports. You can also follow us on Twitter @spieltimes for the latest PS5 restock and drop. Until next time, Stay Safe and Happy Gaming!
Leslie Cruz
Meet Leslie, a passionate content writer who has a deep love for all things entertainment. She has a keen interest in video games, especially MMORPGs and MOBAs. She enjoys exploring different worlds, battling monsters, and competing with other players in online gaming communities. In her downtime, Leslie also loves to binge-watch anime and Netflix shows. She finds joy in immersing herself in different storylines, whether it be heartwarming romantic comedies or thrilling sci-fi adventures. Leslie is also a fan of celebrity rumors and gossip. She enjoys staying up-to-date on the latest news and scandals in the entertainment industry. When she's not writing about games, anime, or celebrity gossip, Leslie can be found watching sports games. She loves the excitement of rooting for her favorite teams and players, and enjoys the camaraderie that comes with being a sports fan. Overall, Leslie is a content writer who is passionate about all things entertainment. Her love for gaming, anime, celebrity news, and sports helps to inspire and inform her writing, and she's always on the lookout for new and exciting topics to explore.
View all articlesRelated Articles
View All
Grand Theft Auto VI Pre-Orders Open Amid Rising Scam Alerts Online
Rockstar Games has confirmed that Grand Theft Auto VI pre-orders will begin on June 25, 2026. The announcement arrives as...

Major Game Reveals and Surprise Returns Headline Summer Game Fest 2026
Big reveals, unexpected comebacks, and plenty of new trailers made Summer Game Fest 2026 a busy night for fans. If...

Grand Theft Auto VI release date confirmed for November 2026
Rockstar Games has officially locked in November 19, 2026, as the release date for Grand Theft Auto VI, bringing an...